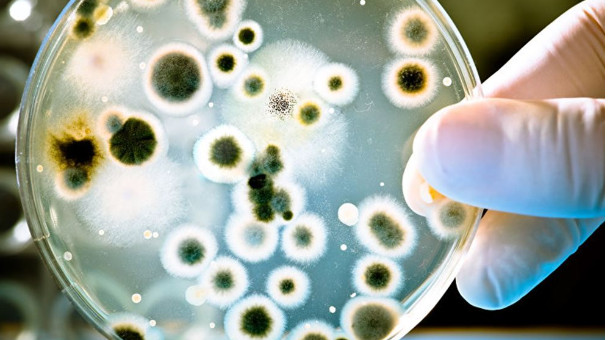

МӨӨГӨНЦӨРИЙН ШИНЖИЛГЭЭНИЙ 19,600 ТӨГРӨГИЙГ ЭМДЕГ-ААС ХАРИУЦНА

Мөөгөнцөр илрүүлэх оношилгооны 70 хувийг ЭМД-ын сангаас хөнгөлнө. ЭМДҮЗ-ийн 2022 оны 01 дүгээр тогтоолоор мөөгөнцөр илрүүлэх оношилгоог 28 мянган төгрөг байхаар зохицуулсан бөгөөд үүний 30 хувийг иргэн өөрөө хариуцан төлнө.
































































.jpg)

Сэтгэгдэл